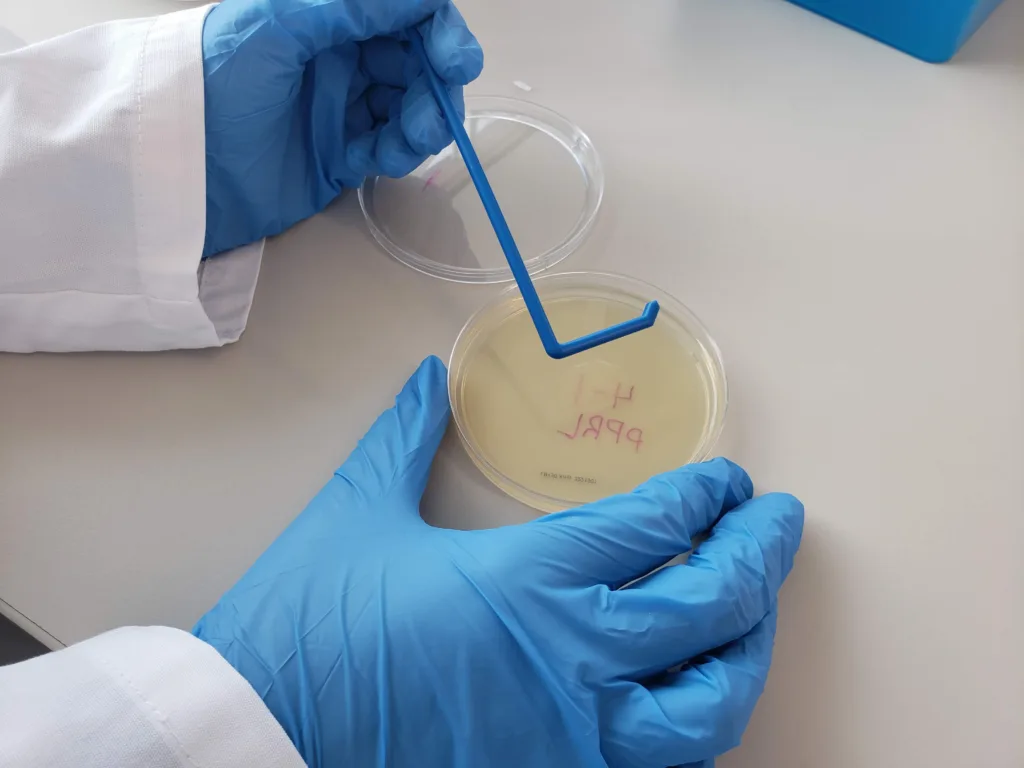
Resources

East Tennessee anchors its synthetic biology hub with BioBuilder
The Dobyns-Bennet High School has 2,500 students and beginning with the class of 2024, all of their graduates will have learned about -- and conducted hands-on experiments in -- synthetic biology. That’s the year when the first class of students who fully experienced the BioBuilder curriculum will be graduating.
Kingsport, Tennessee is undergoing a ground-shifting change in their high school STEM education.
Science teachers Amanda Blackburn and Evie LaFollette have been the momentum behind the integration of BioBuilder into the high school’s STEM curricula. These amazing educators completed the BioBuilder teacher training at the Learning Lab@LabCentral in the spring of 2019. The workshops are co-taught by a practicing synthetic biologist and a high school teacher, and combine classroom, laboratory, and design activities that are accessible and inspiring. Upon completing the training, the Tennessee teachers left with ready-to-teach lessons to bring engineering into their biology classrooms. When they returned to Kingsport, they were more than excited to begin introducing their students to synthetic biology. To support the growing excitement around synthetic biology, BioBuilder held another teacher training in Tennessee in June of 2019, further helping to prepare the teachers for their fall classes.


They began integrating BioBuilder into a few freshman biology classes in the fall of 2019. Fast forward to 2021 and all 9th grade biology classes include the BioBuilder curriculum. Because biology is a required course for graduation, this means that each student—from those pursuing a core education through special education to honors education—will have synthetic biology in their repertoire.
Ms. Blackburn and Ms. LaFollette can tell story after story of how BioBuilder has prompted dramatic student mind shifts. Just a taste of synthetic biology learning combined with real-life hands-on experiments are creating enthusiasm, confidence, and career dreams in their students. “Students now ask us when and how they can do more synbio work,” say the teachers, “they even come up with their own synbio studies.” You can’t ask for any better testimonials than that!


The synbio buzz in Tennessee is getting so strong that teachers Evie and Amanda are making plans to complete BioBuilder’s Master Teacher Training so they can be even more helpful for other teachers and school systems. “Natalie and her team bring a personal element to BioBuilder that other programs don’t have,” say Blackburn and LaFollette, “making a very open and encouraging atmosphere for teachers when they begin to delve into synbio.”
Organic Regional Synbio Growth
The Kingsport successes have not gone un-noticed. As other school systems in the region hear how students are embracing synthetic biology, they are investigating how BioBuilder can be integrated into their own science classes. It isn’t unusual for Blackburn or LaFollette to get a phone call from a teacher with questions about an experiment or just wanting to talk about the lessons.
Additionally, the Tennessee STEM Innovation Network has asked LaFollette and Blackburn to host a teacher professional development training on BioBuilder. “We want to help more teachers understand how to implement BioBuilder,” they explain, “and realize that they don’t have to have a state-of-the-art science facility to do so.”
In December 2020, Tennessee educational powerhouse, the Niswonger Foundation, received $8M of federal funds from the Department of Education to bring a portfolio of STEM programs to the region, with BioBuilder among them. Over the next five years, this partnership promises to bring game-changing science curriculum to 21 school districts, impacting as many as 57,000 students in the area, according to David Golden, Niswonger Foundation board member and ETSU Research Corporation CEO. These efforts promise to make the goal of “enhancing the region, impacting the world” a reality.
East Tennessee is rapidly developing into a synthetic biology hub. East Tennessee State University has launched a future-focused strategic vision that will further leverage regional talent for the benefit of the Appalachian Highlands community.
BioBuilder is all-in to support east Tennessee in realizing their synthetic biology goals. Our efforts can help engage students at the high school level so they can pursue these interests through exceptional synbio college education at ETSU. The growing synthetic biology industry in east Tennessee can then provide career opportunities for regional graduates.

We see the school-system and region-wide approaches to synbio as models for many other regions looking to grow their bioeconomies. What a great goal to be working on together!
For those interested in participating in BioBuilder’s Professional Development Workshops, keep an eye on our website for the announcement of a new, hybrid-remote option we’ll offer this summer – details to be posted in the coming weeks!
